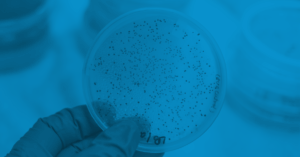
viewing Bacterial Endotoxins in a Petrie dish

Comparing Microbiology Testing with Bacterial Endotoxins
An endotoxin is what?
The term “endo” in endotoxin denotes an internal entity. Endotoxin’s “toxin” component refers to a poisonous substance. Endotoxins are produced by the cell walls of gram-negative bacteria and can be fatal to humans. The endotoxins themselves are molecules that contain complex sugars (also called polysaccharides) and fats (lipids). Endotoxins are sometimes referred to as lipopolysaccharides (LPS) in scientific literature because of their fat and sugar components. Because endotoxins generate fever when released into the human body and activate the innate immune system, they are also regarded as pyrogens.
Microbiology: What is it?
Microbiology is derived from the Greek and Latin words “micro,” “bio,” and “ology.” Small is represented by the letter “micro,” biology by the letter “bio,” and “the study of” by the letter “ology.” The term “microbial,” which describes microorganisms, can also be used to describe microbiology. Imagine combining the definition of “microbial” with all of those Latin and Greek roots. In that instance, we know that microbiology is the study of microbes, which are tiny living elements that make up the vast area of life.
What is the connection between microbiology and endotoxins?
Determining the species and genus of various microorganisms in a sample is the focus of microbiology. Microbiology uses colony-forming units (CFUs) to measure the quantity of microorganisms in a sample. Endotoxins, on the other hand, are unique to gram-negative bacteria. It is not the gram-negative bacteria themselves that are hazardous, but rather their endotoxins. Gram-negative bacteria of a specific type can be identified by microbiology. However, regulatory microbiological testing would not reveal endotoxin levels.
What distinguishes microbiology testing from bacterial endotoxin testing?
The presence and amount of endotoxins in a given sample are determined by bacterial endotoxin testing. Microbiology testing, on the other hand, determines the kind and quantity of microorganisms present in an industrial setting, medical device, or product. Assays like microbial enumeration testing, particulate analysis, yeast analysis, zone of inhibition testing, growth promotion testing, microbial limits testing, zone of inhibition testing, water analysis, bacteriostasis/fungistasis testing, gram-negative staining, product inoculations, biological indicator tests, BI incubation time reduction studies, and microbial enumeration testing are examples of specific regulatory testing for microbiology.
Microbiology testing is governed by USP 61 and USP 62. On the other hand, the procedures described in USP 85 are used in bacterial endotoxin testing. It should be noted that conventional microbiology tests cannot determine whether endotoxins are present in a sample or the extent of bacterial endotoxin contamination.
Why are tests for microbiology and bacterial endotoxins both crucial?
Testing for bacterial endotoxins is a crucial quality control procedure that determines a product’s degree of endotoxin contamination at any point, from the product’s initial manufacturing to its ultimate distribution. Bacterial endotoxins can be unintentionally introduced during the manufacturing or packing process in a variety of ways because germs are present on every surface, including human bodies. The most frequent examples are contamination from technicians, raw materials, tubing or pipe used to move products between stages of a process, or the actual manufacturing environment. Regular endotoxin testing aids in the long-term management of production sites because there are so many sources of contamination. The main purpose of bacterial endotoxin testing is for medical devices or goods that will be implanted into human bodies. Assume bacterial endotoxins are present in an injectable product or on the surface of a medical device or product. The exposed patient’s innate immune system will then become active, resulting in fever, chills, and maybe even death.
In manufacturing settings, particularly aseptic manufacturing settings, microbiological testing is essential for reducing the risk of contamination and preventing product-induced infections. Because aseptic processing necessitates removing microorganisms from the manufacturing processes, aseptic manufacturing settings rely significantly on microbiological testing. Therefore, during aseptic processing, it is necessary to keep microorganisms out of open containers or product components. Therefore, clean rooms and facilities that use aseptic processes to make products are monitored by microbiological testing.
In Brief
Microbiology and bacterial endotoxin testing are essential for a medical device or product to receive regulatory approval. Toxin-free medical devices and products are guaranteed by these tests, protecting patients against infection or pyrogenesis after device exposure or product implantation. Make sure the contract testing company you select can assist you with the proper bacterial endotoxin and microbiological testing for your particular medical device or product requirements.






